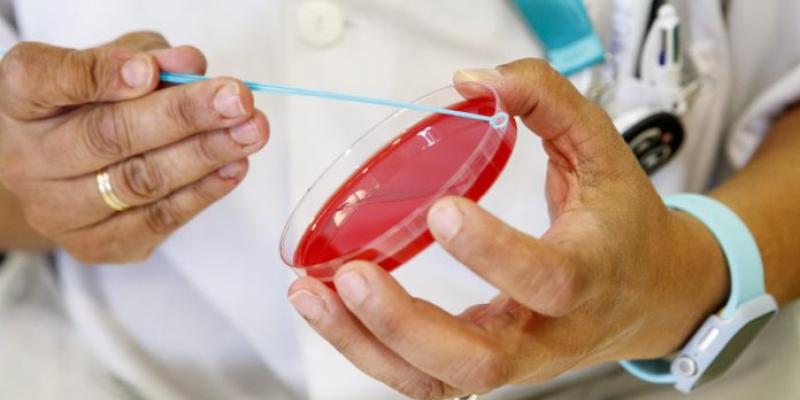
Aumentan los casos de sífilis

Lectura fácil
Las autoridades de salud pública alertan sobre un aumento preocupante de la sífilis en el país: durante el último año, los casos de sífilis crecieron un 71 % respecto del promedio de los cinco años anteriores, según cifras oficiales del Boletín Epidemiológico Nacional. El incremento afecta a la población general y también a mujeres embarazadas, lo que refuerza la necesidad de fortalecer la prevención, la detección temprana y la educación sexual.
Aumento preocupante de los casos de sífilis en el país
Las autoridades de salud pública vienen señalando desde hace tiempo la necesidad de prestar atención a la sífilis, y los datos oficiales del último año confirman sus advertencias. Esta enfermedad de transmisión sexual registró un incremento significativo durante 2025, con un aumento del 71 % en comparación con el promedio de los cinco años anteriores. Los especialistas coinciden en que la tendencia es alarmante y requiere acciones inmediatas de prevención y concientización.
El Boletín Epidemiológico Nacional indicó que los registros de casos de sífilis superaron ampliamente las cifras históricas recientes. La información consolida una tendencia ascendente que preocupa a los profesionales de la salud y pone de relieve la importancia de mantener controles sistemáticos y programas de educación sexual.
De acuerdo con el Ministerio de Salud, los casos de sífilis en la población general alcanzaron en 2025 un total de 46.613, frente a una mediana de 27.232 entre 2020 y 2024. Esto representa un incremento de 19.381 infecciones, equivalente al 71 % respecto del promedio quinquenal.
Los especialistas explican que la propagación de la enfermedad se ve favorecida por conductas de riesgo, como la disminución en el uso de preservativos, y por la falta de campañas sostenidas sobre infecciones de transmisión sexual. Esta combinación reduce la percepción de riesgo, especialmente entre adolescentes y adultos jóvenes.
Sífilis en embarazadas
El boletín epidemiológico también evidencia un crecimiento en los casos de sífilis durante el embarazo. En 2025 se confirmaron 11.261 infecciones en gestantes, frente a una mediana histórica de 9.821 entre 2020 y 2024, lo que refleja un aumento del 15 %. La transmisión vertical de madre a hijo es una de las formas más críticas de contagio, y subraya la importancia del control prenatal y la detección temprana.
La sífilis es causada por la bacteria Treponema pallidum. Se transmite principalmente a través del contacto sexual sin protección, aunque también puede pasar de madre a hijo durante la gestación. En sus etapas iniciales, la infección puede presentar síntomas leves o incluso ser asintomática, lo que facilita su propagación silenciosa. Si no se trata a tiempo, puede afectar órganos importantes, incluyendo el sistema neurológico y cardiovascular.
Fases y prevención
La enfermedad se desarrolla en varias etapas. La primera señal suele ser un chancro indoloro, que puede aparecer en los genitales, la boca, los labios o la lengua. Aunque esta lesión desaparece espontáneamente, la bacteria permanece en el organismo.
El grupo más afectado se encuentra entre los 15 y 34 años, con mayor incidencia en la franja de 15 a 40 años en La Pampa. Sin embargo, los casos de sífilis pueden presentarse a cualquier edad, y las autoridades insisten en la importancia del diagnóstico oportuno, el uso del preservativo y el tratamiento adecuado.
Los profesionales recomiendan reforzar la educación sexual y mantener campañas constantes de prevención. Solo así será posible controlar el aumento de casos de sífilis y de otras infecciones de transmisión sexual. La vigilancia epidemiológica, combinada con el compromiso de la población, constituye la mejor estrategia para reducir la propagación de la enfermedad y proteger la salud de todos.



Añadir nuevo comentario